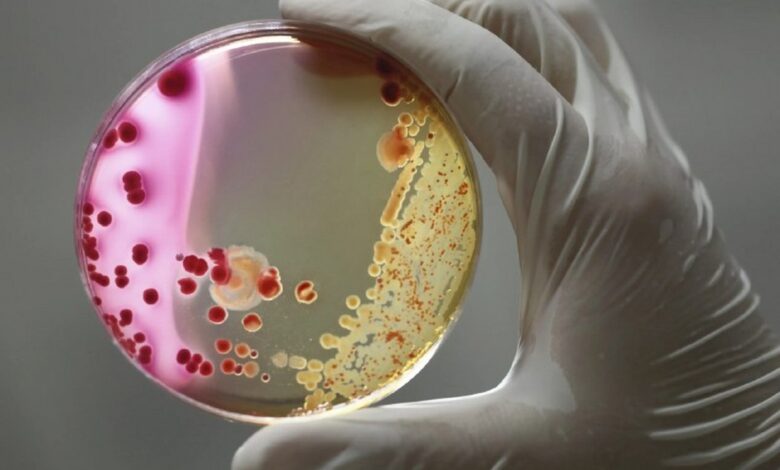

Эти бактерии подстерегают в душевых и саунах, скапливаются в водонагревателях и почве для рассады. Они мало изучены и тяжело поддаются лечению.

О микобактериозе легких, факторах развития заболевания и группах риска 24health.by рассказала ведущий научный сотрудник отдела пульмонологии и хирургических методов лечения болезней органов дыхания РНПЦ пульмонологии и фтизиатрии, кандидат мед. наук, доцент Людмила Богуш.
Что такое микобактериоз легких
Это относительно новое инфекционное заболевание, вызванное нетуберкулезными микобактериями (микробами, близкородственными микробам туберкулеза. Их более 200 видов, 60 из которых являются клинически значимыми, то есть способными вызвать инфекцию). Близкородственное туберкулезу заболевание, но не туберкулез. Болезни могут быть схожи по проявлениям, но отличаются по возбудителю, эпидемиологии и социальной значимости.

Ежегодно в мире наблюдается прирост пациентов с этой патологией (до 8% в год). Причем заболеваемость растет параллельно с одновременным снижением туберкулеза, и рост в первую очередь показывают страны с развитой системой здравоохранения, т.к. там лучше развита диагностика.
Более высокая заболеваемость на сегодняшний день наблюдается в прибрежных районах; в Восточной Азии, Северной Америке и Австралии выше, чем в Европе.
Движущие силы роста этой инфекции остаются неясными. Врачи не могут пока объяснить, почему у одного пациента развивается болезнь, а у другого нет.
Предпосылки развития микобактериоза легких

Развитию микобактериоза легких могут способствовать следующие проблемы и состояния.
Хронические заболевания органов дыхания:
- ХОБЛ,
- астма,
- бронхоэктатическая болезнь,
- рак легких,
- курение,
- рецидивирующая аспирация с гастроэзофагиальной рефлюксной болезнью,
- ингаляционные кортикостероиды,
- легочный фиброз,
- муковисцидоз,
- деформация грудной клетки,
- анкилозирующий спондилит — болезнь Бехтерева,
- сколиоз,
- перенесенный туберкулез и т.д.
Системный иммунодефицит:
- ВИЧ-инфекция,
- состояние после трансплантации органов,
- злокачественные новообразования (гематологический рак),
- алкоголизм,
- кахексия,
- иммуносупрессивная терапия (например, кортикостероиды и некоторые противоопухолевые препараты),
- прорезывание зубов (у детей с шейным лимфаденитом),
- возраст (маленькие дети и пожилые люди),
- мужской пол,
- сахарный диабет,
- почечная недостаточность.
А также развитию заболевания может способствовать повышенная генетическая восприимчивость из-за мутаций некоторых генов.
Группы риска
- У пациентов с любым типом хронической болезни органов дыхания риск поражения нетуберкулезными микобактериями органов дыхания увеличивается в 16,5 раза.
- Так, бронхоэктатическая болезнь увеличивает вероятность заболевания на 70%, ХОБЛ на 19%.
- Большинство пациентов с окончательным диагнозом «микобактериоз легких» – это люди 40–70 лет, худые с индексом массы тела ниже 18 — микобактерии не любят жировую ткань.
- Сопутствующие заболевания органов дыхания имеет каждый 5-й пациент.
Заразно ли это?
Нет, не заразно. Человек с микобактериозом легких не представляет эпидемиологической опасности, не должен обязательно находиться в изоляции.
Лечение таких пациентов может проводиться в амбулаторных, стационарных условиях или отделениях дневного пребывания. Если лечащий врач разрешит, то можно совмещать лечение с работой или учебой.
Заражение нетуберкулезными микобактериями происходит из окружающей среды аэрогенным способом, контактным при повреждении кожных покровов, а также пищевым и водным путями.
Основной источник нетуберкулезных микобактерий – душевые комнаты, сауны, джакузи, бани. Передача микроорганизмов от человека к человеку не характерна, но не исключена.
Диагностика и лечение

Диагностические обследования и лечение назначает врач-фтизиатр (направить к этому специалисту может участковый терапевт, врач общей практики и др.).
Диагностировать микобактериоз легких непросто из-за различной вирулентности (степени ядовитости) нетуберкулезных бактерий, неустойчивого выделения патогена. Вся необходимая диагностика может занять год и более.
Признаки болезни могут быть разными: от полного отсутствия симптомов до выраженных респираторных (кашель с мокротой или сухой, кровохарканье, одышка) и общих интоксикационных (лихорадка, ночная потливость, похудение, усталость) жалоб разной степени выраженности.
Заболевание склонно к хроническому рецидивирующему течению.
На сегодняшний день основным методом лечения является химиотерапия. Схема химиотерапии и режимы лечения зависят от вида нетуберкулезной микобактерии, формы и лекарственной чувствительности. При этом химиотерапия показана не всем пациентам и не все могут ее перенести. Используется персонифицированный подход к лечению.
Профилактика микобактериоза легких
- Людям из группы риска не следует использовать фильтры с гранулированным активированным углем на кранах и душевых головках. Лучше специализированные фильтры с размером частиц 0,2 мкм, которые отфильтровывают нетуберкулезные микобактерии (учитывайте, что они могут засоряться, и их необходимо часто менять).
- Следует избегать использования льдогенераторов в холодильниках.
- Душевые головки и аэрозоли для душа содержат высокие концентрации микобактерий. Нетуберкулезные микобактерии сильнее прилипают к биопленке пластиковых душевых головок, чем металлических. Нужно проводить регулярную ручную чистку, а затем дезинфицировать, погрузив в кипящую воду или в неразбавленный отбеливатель на 30 минут.
- Лучше использовать душевые головки с отверстиями большего диаметра, чем те, которые производят туман с более мелкими частицами.
- Необходимо минимизировать время, проводимое в душе, и как можно чаще проветривать ванную комнату. Водонагреватели следует регулярно сливать, так как осадок, который скапливается на дне бака, содержит самую высокую концентрацию нетуберкулезных микобактерий, а температура водонагревателя должна поддерживаться на уровне 49°С (120°F). Увлажнители заполнять либо стерильной водой, либо предварительно кипяченой водой, которая затем охлаждается до комнатной температуры.
- Избегайте посещения гидромассажных ванн и паровых бань. Помните также, что воздух над крытым бассейном содержит больше нетуберкулезных микобактерий, чем сама вода.
- Людям, занимающимся садоводством, рекомендовано увлажнять почву для рассады перед ее использованием, чтобы уменьшить образование пылевых аэрозолей, и по возможности надевать маску. Микобактерии были обнаружены в природной и коммерческой почве и торфе, а также их аэрозолях с концентрацией до одного миллиона организмов на грамм.
- Соблюдайте осторожность при контакте с бытовой и пылесосной пылью, в которой также содержатся нетуберкулезные микобактерии.

